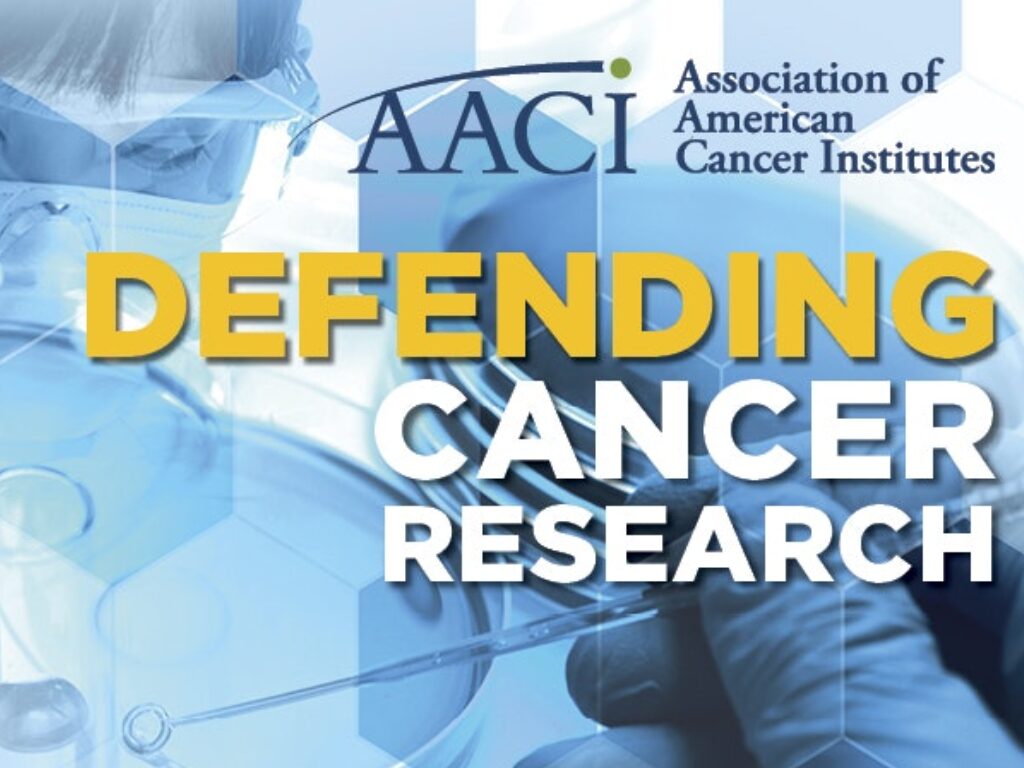
Defending Cancer Research banner 1024x768

Press Room
Visit the press room to view recent media coverage and read press releases and statements.
Media Contacts
Chris Zurawsky, MS, MPPM
Director of Communications
[email protected]
Emily E. Stimmel, MA
Communications and External Relations Manager
[email protected]
AACI Update
AACI's monthly newsletter features the latest news from North America's leading academic cancer centers, plus job postings and an events calendar.
AACI Commentary
The Commentary is AACI's monthly editorial series, in which cancer center leaders and subject matter experts explore topics that matter to AACI members.
Defending Cancer Research
In the Defending Cancer Research digest, AACI collects and shares local and national stories covering the impact of cancer research funding on patients and communities.
Annual Report
AACI's annual report highlights accomplishments of its programs and initiatives and acknowledges the support of corporate and sustaining members.